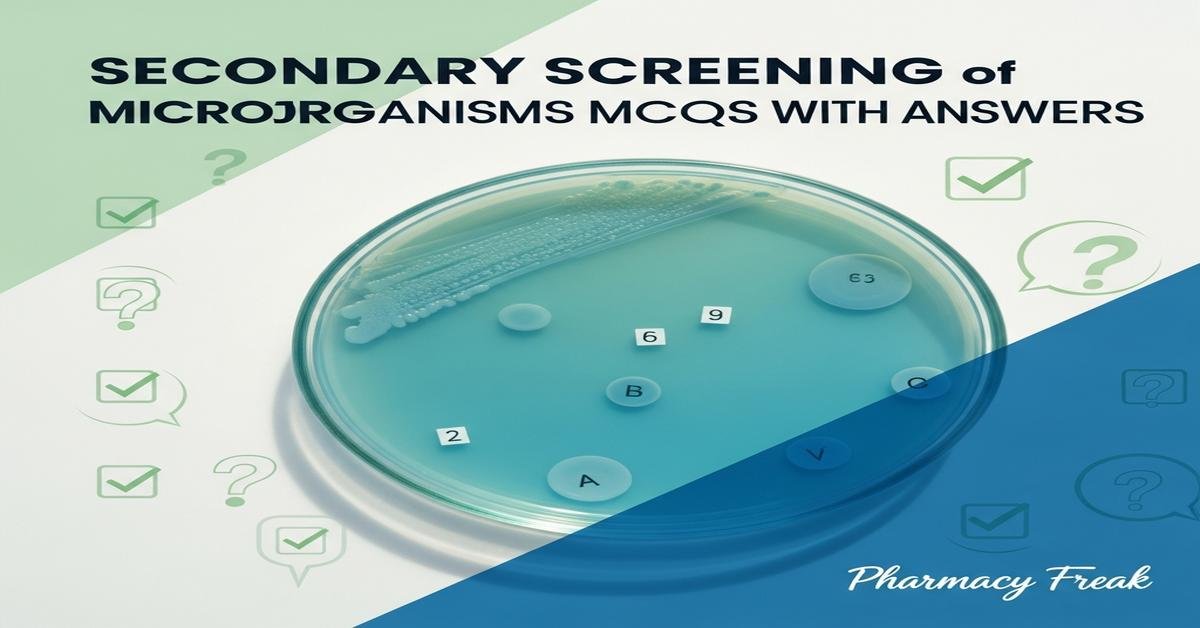
Secondary screening of microorganisms MCQs With Answer

Secondary screening of microorganisms MCQs With Answer
Introduction: Secondary screening is a critical stage in bioprocess development where promising microbial isolates identified in primary screens are rigorously evaluated for consistent production, potency, and suitability for scale-up. For M.Pharm students, understanding secondary screening involves learning quantitative assays (MIC, broth microdilution), plate-based and liquid bioassays, optimization strategies, analytical confirmation (HPLC, GC-MS), and selection criteria such as genetic stability and productivity. This blog offers focused multiple-choice questions that probe deeper aspects—assay design, indicator strain choice, fermentation parameters, co-culture effects, statistical optimization, and downstream considerations—helping students build practical and conceptual skills needed for research and industrial bioprocess applications.
Q1. What is the primary objective of secondary screening of microorganisms?
- To rapidly isolate new environmental strains
- To perform genome sequencing of isolates
- To evaluate and quantify bioactive compound production under controlled conditions
- To test toxicity of crude environmental samples
Correct Answer: To evaluate and quantify bioactive compound production under controlled conditions
Q2. Which secondary screening method is most appropriate to determine the minimum inhibitory concentration (MIC) of an antibiotic produced by a strain?
- Agar well diffusion assay
- Disk diffusion assay
- Broth microdilution assay
- Cross-streak plate assay
Correct Answer: Broth microdilution assay
Q3. What is the key consideration when selecting indicator strains for antimicrobial secondary screening?
- Use of only Gram-positive clinical isolates
- Selection of strains that are genetically identical to the producer
- Choosing clinically relevant and sensitive strains to the target compound
- Preference for environmental, non-pathogenic strains only
Correct Answer: Choosing clinically relevant and sensitive strains to the target compound
Q4. During secondary screening, why is fermentation parameter optimization performed?
- To identify the taxonomic identity of the microorganism
- To maximize metabolite yield by varying parameters like pH, aeration and nutrients
- To reduce the need for downstream purification
- To eliminate the need for analytical confirmation
Correct Answer: To maximize metabolite yield by varying parameters like pH, aeration and nutrients
Q5. Which medium modification commonly enhances antibiotic production during secondary screening?
- Increasing phosphate concentration to maximum levels
- Altering carbon source concentration and carbon:nitrogen ratio
- Using only rich, undefined media without limitation
- Maintaining extreme alkaline pH throughout fermentation
Correct Answer: Altering carbon source concentration and carbon:nitrogen ratio
Q6. What is the purpose of replica plating in secondary screening of mutant libraries?
- To sequence DNA of each colony
- To transfer colonies to selective media and detect metabolite production without destroying original colonies
- To perform large-scale fermentation directly
- To measure protein concentrations in colonies
Correct Answer: To transfer colonies to selective media and detect metabolite production without destroying original colonies
Q7. Which technique is suitable for detecting extracellular enzyme activity during secondary screening on solid media?
- Plate assay with substrate and indicator dye showing zones of clearance or color change
- Direct genomic PCR of colonies only
- Electron microscopy of colony edges
- Gram staining of producing colonies
Correct Answer: Plate assay with substrate and indicator dye showing zones of clearance or color change
Q8. Why is Response Surface Methodology (RSM) used in secondary screening optimization?
- To identify microbial taxonomy from metabolic profiles
- To determine interaction effects among variables and find optimal conditions efficiently
- To replace analytical techniques like HPLC
- To increase the number of isolates screened qualitatively
Correct Answer: To determine interaction effects among variables and find optimal conditions efficiently
Q9. What is the usual next scale-up step after promising results in shake-flask secondary screening?
- Direct industrial-scale fermenter use
- Bench-top (laboratory) bioreactor studies for controlled parameter testing
- Abandoning fermentation and moving to chemical synthesis
- Performing only plate-based assays at larger plates
Correct Answer: Bench-top (laboratory) bioreactor studies for controlled parameter testing
Q10. Why are negative and positive controls essential in secondary screening assays?
- They increase colony numbers on plates
- They validate assay specificity and help rule out false positives from media or solvents
- They eliminate the need for replicates
- They ensure all strains show activity
Correct Answer: They validate assay specificity and help rule out false positives from media or solvents
Q11. The cross-streak assay is primarily used in secondary screening to detect what?
- Production of intracellular enzymes only
- Antagonistic activity between producing strain and test organism
- The color of secondary metabolites
- Exact molecular weight of the compound
Correct Answer: Antagonistic activity between producing strain and test organism
Q12. Which parameter best reflects production efficiency during secondary screening?
- Final optical density (OD) only
- Total incubation time only
- Specific production rate (product per biomass per time)
- Colony color on agar
Correct Answer: Specific production rate (product per biomass per time)
Q13. Which analytical technique is commonly used in secondary screening for quantification and purity assessment of non-volatile metabolites?
- Light microscopy
- HPLC (High-Performance Liquid Chromatography)
- Gel electrophoresis
- Flame photometry
Correct Answer: HPLC (High-Performance Liquid Chromatography)
Q14. For identification of volatile secondary metabolites produced in fermentation, which technique is most appropriate?
- UV-Visible spectroscopy
- GC-MS (Gas Chromatography–Mass Spectrometry)
- Plate streaking
- Polarimetry
Correct Answer: GC-MS (Gas Chromatography–Mass Spectrometry)
Q15. Which trait is most critical when selecting a high-producing strain for further development?
- Unstable high yield that declines after a few passages
- Genetic stability and consistent high yield across subcultures
- Slow growth with unpredictable yields
- Production only on extremely expensive media
Correct Answer: Genetic stability and consistent high yield across subcultures
Q16. What is a widely used long-term preservation method for selected high-producing microbial strains after secondary screening?
- Continuous culture at room temperature
- Glycerol stocks stored at −80°C
- Repeated subculturing on agar weekly
- Drying at 37°C without cryoprotectants
Correct Answer: Glycerol stocks stored at −80°C
Q17. How can co-culture strategies during secondary screening benefit discovery of new metabolites?
- They always suppress metabolite production
- They can induce expression of silent biosynthetic pathways via interspecies interactions
- They simplify downstream purification by removing impurities
- They eliminate the need for analytical verification
Correct Answer: They can induce expression of silent biosynthetic pathways via interspecies interactions
Q18. Which indicator dye is commonly used to detect pH changes associated with metabolite production in plate assays?
- Coomassie Brilliant Blue
- Phenol red
- Silver nitrate
- Methylene chloride
Correct Answer: Phenol red
Q19. Which method is appropriate for secondary screening of antifungal activity on solid media?
- Dual culture assay on potato dextrose agar (PDA)
- Sequencing fungal genomes only
- Measuring gas production in liquid broth
- Acid-fast staining
Correct Answer: Dual culture assay on potato dextrose agar (PDA)
Q20. In antimicrobial plate assays, what does the term “zone of inhibition (ZOI)” represent?
- The region of enhanced microbial growth
- A clear area around a colony or disk indicating inhibition of the test organism
- The color change produced by metabolic activity
- Thickness of the microbial lawn
Correct Answer: A clear area around a colony or disk indicating inhibition of the test organism